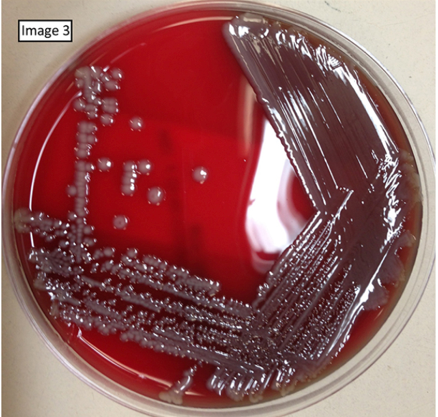

Uworld Notes 2
Bursitis

A bursa is a fluid-filled synovial sac that serves to alleviate pressure and friction at bony prominences and ligamentous attachments throughout the body. Bursae are vulnerable to injury from acute trauma or chronic repetitive pressure and may also become inflamed due to infection (septic bursitis), crystalline arthropathy (eg, gout), or autoimmune conditions (eg, rheumatoid arthritis). Because bursae are located in prominent and exposed positions, the pain of bursitis may be exquisite, and point tenderness is typical. Other features of bursitis may include swelling and erythema, particularly with more superficial bursae. Active range of motion is often decreased or painful, but passive motion is usually normal as it results in less pressure on the inflamed bursa.
This patient with acute pain and localized tenderness associated with repetitive anterior knee trauma from kneeling has typical features of prepatellar bursitis, sometimes called "housemaid's knee." The prepatellar bursa is located between the patella and the overlying skin. Other occupations associated with prepatellar and infrapatellar bursitis include carpet layers, mechanics, and plumbers.
(Choice A) Anserine bursitis presents with pain along the medial knee and well-defined tenderness approximately 4 cm distal to the anteromedial joint margin of the knee. It frequently results from obesity or overuse in athletes.
(Choices B and D) Popliteal (Baker) cysts are caused by swelling of the gastrocnemius or semimembranosus bursa. They often form due to extrusion of synovial fluid from the knee joint into the bursa in patients with osteoarthritis or inflammatory joint disease.
(Choice E) The suprapatellar bursa is located anteriorly between the distal femur and quadriceps. Bursitis here is most often caused by a direct blow to the distal thigh or prolonged/repetitive quadriceps activity (eg, running).
NSAIDS
All of the agents listed are non-steroidal anti-inflammatory drugs (NSAIDs), medications commonly used to treat pain, arthritis, and fever. NSAIDs work by inhibiting the enzyme cyclooxygenase (COX), thus blocking prostaglandin synthesis. Most NSAIDs inhibit both the COX 1 and COX 2 isoenzymes. Whereas COX 1 plays a physiologic role in a number of normally functioning tissues (e.g. platelets, the gastrointestinal tract), COX 2 is preferentially expressed at sites of inflammation. Many of the potential NSAID adverse effects, including GI ulceration and bleeding, are related to inhibition of COX 1. Selective COX2 inhibitors were developed to avoid these complications. In a patient with pain, fever, and hematuria, a selective COX 2 inhibitor, such as celecoxib, would be an appropriate choice.
Both COX 1 and COX 2 are expressed in renal tissues. Both traditional NSAIDs and selective COX 2 inhibitors can cause fluid retention and aggravation of hypertension.
The COX 2 enzyme is also expressed in vascular endothelial cells and vascular smooth muscle cells, and may play a role in the local production of prostacyclin (PGI2), a substance that promotes anticoagulation and vascular dilatation. Some selective COX 2 inhibitors have been associated with an increased incidence of cardiovascular events, which may be related to decreased production of PGI2.
Back Muscles
The arrow points to a bilaterally symmetric structure that lies in close association to the vertebral body and vertebral transverse process. This is the psoas muscle, which originates from the anterior surface of the transverse processes and lateral surface of the vertebral bodies at T12-L5. Inferiorly (at around the level of the inferior ligament), the psoas muscle combines with the iliacus muscle(Choice B) to form the iliopsoas muscle, which functions in hip flexion. Intraabdominal or more distal infections can spread to these muscles (eg, psoas abscess) and cause abdominal pain, fever, and weight loss. HIV, intravenous drug use, and diabetes are risk factors for primary psoas abscess development.


(Choice A) The erector spinae (also shown in the image above) is a large muscle group of the back that courses longitudinally along the spinous processes. Bilateral contraction causes spine extension.
(Choice C) The ligamenta flava are paired elastic ligaments that connect the vertebral laminae. The ligamenta flava form the posterior wall of the spinal canal and help hold the body erect.
(Choice E) The transversus abdominis (transversalis) muscle is the most internal component of the anterior abdominal wall musculature. It lies immediately deep to the internal oblique and provides support to abdominal contents during respiration without interfering with rib cage movement.
CTLA
CTLA-4 also binds to B7 but has an inhibitory function on activated T cells.

Programmed death receptor 1 (PD-1) is expressed on the surface of activated T cells. It binds to its ligand, programmed death ligand 1 (PD-L1), downregulating the immune response against tumor cells primarily by inhibiting cytotoxic T cells (similar to cytotoxic T lymphocyte-associated protein 4 [CTLA-4]). Many types of cancer cells evade the immune system by increasing expression of PD-L1. Monoclonal antibodies against PD-1 have been developed that prevent the binding of PD-1 to PD-L1; this blocks T cell inhibition, thereby restoring the cytotoxic response and promoting apoptosis of tumor cells. Anti-PD-1 therapy is used in advanced melanoma and certain types of lung cancer.
Anal Fissures

This patient has sharp pain and bright red rectal bleeding on defecation, suggesting an anal fissure. Anal fissures are due to stretching of the mucosa and are characterized by longitudinal tears in the anal canal distal to the dentate line (Choice B). Spasm of the sphincter can contribute to the pain and create tension across the wound, leading to a chronic fissure. Most fissures are related to chronic constipation with high anal pressures and passage of hard stools. They can also be seen with frequent diarrhea or anal sexual intercourse. In some cases, the pain may be so severe that patients withhold bowel movements, thereby exacerbating the constipation.
The majority of fissures, especially those causing prolonged symptoms, occur at the posterior midline of the anal verge. This is likely due to the relatively poor perfusion of the posterior anal canal, which makes its mucosa sensitive to trauma and slows healing times. Anterior midline fissures are less common, but may occur due to mechanical stresses related to the alignment of muscular fibers in the external sphincter (Choice A).
Fissures not at the midline are more likely due to unusual causes (eg, inflammatory bowel disease, malignancy, infection) and may warrant more detailed investigation.
Intoxication
The colleague's immediate supervisor should be informed so that the situation can be dealt with as quickly as possible.
In a non-emergency situation, a person should contact the designated hospital committee, commonly called a physician health program (Choice E). If this is not possible or such a body does not exist, then the state licensing board should be contacted (Choice F).
Cervicitis

Urine Pregnancy Test
A urine pregnancy test is less sensitive than a serum pregnancy test; it becomes positive when β-hCG reaches 20 IU/L, which typically occurs 14 days following fertilization.
ACL, PCL

Sarcomere

A sarcomere is composed of overlapping filaments of actin and myosin as well as structural and binding proteins (eg, titin, α-actinin). A single sarcomere is defined as the distance between two Z lines. Thin (actin) filaments are bound to structural proteins at the Z line. The unbound ends of the actin filaments project into the middle of the sarcomere, where they interact with thick (myosin) filaments during muscle contraction.
Vasectomy

Vasectomy involves transection of the vas deferens. The vas deferens functions not only as a transport duct from the epididymis to the ejaculatory duct but also serves to store and protect sperm following spermatogenesis.
Vasectomy blocks the transport of new sperm from the epididymis but has no effect on sperm distal to the ligation. Patients can still have viable sperm in the distal vas for 3 months and at least 20 ejaculations following vasectomy. Sexual intercourse can typically be resumed within a week following the procedure, but pregnancy is still possible as viable sperm may be present in the ejaculate. Therefore, another method of birth control must be used after vasectomy until semen analysis confirms azoospermia.
Cavernous Sinus

Cavernous sinus thrombosis is most commonly due to contiguous spread of an infection from the medial third of the face, sinuses (ethmoidal or sphenoidal), or teeth. The infection can communicate in a retrograde fashion into the cavernous sinus through the valveless facial venous system (via the superior and inferior ophthalmic veins). Common pathogens include Staphylococcus aureus(most common) and streptococci, although fungal organisms (eg, Mucor, Rhizopus) are responsible in rare cases.
Patients typically experience headache, fever, and diplopia. Ocular muscle paralysis occurs due to injury of cranial nerves (CNs) III, IV, and VI. CN III palsy may also result in ptosis and mydriasis. Involvement of the ophthalmic and maxillary branches of CN V can cause loss of both upper facial sensation and the afferent limb of the corneal reflex. Proptosis (eye protrusion) and chemosis (conjunctival swelling) may also be evident due to impaired venous drainage through the ophthalmic veins.
Liver Biopsy
(Choice A) Serious acetaminophen overdose is characterized by liver failure with centrilobular necrosis that can extend to include the entire lobule.
(Choice B) Alcoholic hepatitis is characterized by hepatocellular swelling and necrosis, Mallory bodies, neutrophilic infiltration, and fibrosis.
(Choice C) Budd-Chiari syndrome is due to occlusion of the hepatic veins with a resulting increase in intrahepatic pressure. Gross findings include hepatomegaly with a tense capsule and reddish-purple parenchyma. Typical microscopic findings include severe centrilobular congestion and necrosis.
(Choice E) Liver disease in hemochromatosis is due to deposition of hemosiderin in the liver. Biopsy is characterized by noninflammatory hepatocyte necrosis with fibrosis.
(Choice F) Reye syndrome is an acute post-infectious disorder characterized by encephalopathy and liver disease. It affects children and is most commonly seen when aspirin is given in the context of an acute viral upper respiratory illness. Biopsy shows panlobular microvesicular steatosis.
RAS
Ras protein is a component of the MAP-kinase signal transduction system. It transmits the stimulus from the receptor on the cell surface into the nucleus.
Ras codes for a G protein that regulates growth factor signal transduction. Mutations that result in a constitutively activated Ras protein cause constant and unregulated cell proliferation, leading to malignancy (particularly pancreatic and colorectal cancer).
Impotence

Psychogenic causes account for approximately 10% of ED cases and include performance anxiety, sexual partner dissatisfaction, marital problems, or other emotional issues. An important clue in psychogenic impotence is rapid onset. Men who had no sexual difficulty until “one night when they could not have an erection,” followed by persistent ED, almost always have psychogenic impotence. In contrast, men suffering from organic causes of impotence complain that failure of sexual function first occurred intermittently and later became more persistent.
The presence or absence of spontaneous erections is another important diagnostic clue. The majority of men experience spontaneous erections during REM sleep and will awaken with an erection, demonstrating the integrity of neurologic reflexes and corpus cavernosa blood flow. Complete loss of nocturnal erections occurs in men with neurologic or vascular disease but is not seen with psychogenic impotence (Choice E).
Muscle Weakness
This patient's fatigability, weight gain, and myoedema (focal mounding of muscle following percussion) make hypothyroidism the most likely cause of his myopathy. Hypothyroid myopathy presents with myalgia, proximal muscle weakness, and cramping. Myoedema is a characteristic finding that occurs in hypothyroid myopathy secondary to slow reabsorption of calcium by the sarcoplasmic reticulum. Serum CK elevation can precede the development of overt hypothyroid symptoms by several years.
Proximal myopathy is common in Cushing syndrome due to increased muscle protein catabolism secondary to high cortisol levels. However, serum CK levels remain normal in Cushing syndrome despite significant proximal muscle weakness.
Severe vitamin D deficiency leading to osteomalacia commonly presents with myalgia, bone pain, and proximal muscle weakness. Weight gain is not a feature of vitamin D deficiency. Muscle atrophy may occur with vitamin D deficiency but serum CK levels are often normal.
Diabetes Death

Several studies have shown that diabetes mellitus is one of the strongest risk factors for coronary heart disease. Cardiovascular mortality is increased by 2- to 4-fold in patients with type 2 diabetes mellitus, and approximately 40% of patients die secondary to coronary heart disease. For a person with type 2 diabetes mellitus, the risk of dying from coronary heart disease exceeds the risk of dying from any of the other listed causes, even in the absence of other major risk factors for coronary heart disease.
Diabetes mellitus is the leading cause of end-stage renal disease (ESRD), followed by hypertension. However, approximately 50% of patients with ESRD die due to cardiovascular disease, with infections being the next most common cause.
(Choice E) The risk of stroke is increased in patients with diabetes mellitus. However, cerebrovascular accidents account for about 10% of total mortality in patients with type 2 diabetes mellitus versus 40% from coronary heart disease.
Vit A

This patient's impaired driving in low light conditions ("night blindness") and thickened, dry skin (hyperkeratosis) are suggestive ofvitamin A deficiency. Dietary intake of vitamin A comes from a combination of beta-carotene, a provitamin found in plants, and preformed vitamin A from animal sources. Vitamin A is necessary for vision (phototransduction, retinal and conjunctival development) and keratinocyte differentiation. Most individuals in the United States have adequate dietary intake of vitamin A, but patients may develop deficiency due to malabsorption related to biliary obstruction, exocrine pancreatic insufficiency, or small-bowel resection (eg, Crohn disease, bariatric surgery).
This patient, a middle-aged woman with generalized pruritus and signs of vitamin A deficiency, likely has underlying primary biliary cholangitis (PBC), a common autoimmune disease characterized by destruction of small bile ducts in the liver. Bile acids are important for solubilization and absorption of fats; patients with chronic biliary obstruction due to PBC may develop malabsorption of fats and fat-soluble vitamins (A, D, E, and K). Patients with PBC frequently have generalized pruritus due to bile acid accumulation in the skin. Visible jaundice is often not apparent until later in the disease course.
Klebslla

clear zone and thick capsule
Hemangioma

The image above shows a strawberry (infantile) hemangioma, a variant of a capillary hemangioma that is the most common benign vascular tumor in children. Superficial infantile hemangiomas are bright-red compressible plaques with sharply demarcated borders and are referred to as strawberry hemangiomas. Deeper infantile hemangiomas have a duskier blue appearance. Individual lesions can have superficial and deep components.
Strawberry hemangiomas appear during the first days or weeks after birth and grow rapidly during the first one to two years of life. The majority of these tumors regress by five to eight years of age. Capillary hemangiomas can be also found in deep tissues and the viscera, especially the liver. On microscopic examination, capillary hemangiomas consist of thin-walled blood vessels with narrow lumens filled with blood and separated by connective tissue. These vessels are lined by endothelium that rapidly proliferates during the growth phase of the tumor.
(Choice B) Cherry hemangiomas are the most common benign vascular proliferations in adults. They are small, bright red, cutaneous papules that appear in patients during adulthood. They consist of dilated capillaries and post-capillary venules in the papillary dermis and do not regress spontaneously.
(Choice C) Spider angiomas are common in pregnancy, liver disease and in patients that take OCPs or estrogen supplements. They are dilated cutaneous arterioles that present as central papule with radiating blanching capillaries.
(Choice D) Cavernous hemangiomas may be present at birth or develop later in life. They present as soft blue compressible masses up to a few centimeters in size. Light microscopy reveals large dilated vascular spaces.
(Choice E) Cystic hygromas (lymphangiomas) are benign tumors that consist of dilated lymphatic spaces lined by endothelium. They most commonly occur on the neck, and on physical exam these tumors are lobulated, compressible and usually transilluminate.
Hand Nerves

This patient's presentation is consistent with ulnar neuropathy. The ulnar nerve is a branch of the medial cord of the brachial plexus derived from the C8-T1 ventral rami. It enters the forearm after passing behind the medial epicondyle of the humerus. Within the forearm, it innervates the flexor carpi ulnaris and the medial portion of the flexor digitorum profundus. The nerve then enters the wrist between the hook of the hamate and the pisiform bone in a fibroosseous tunnel known as Guyon's canal. Here, it divides into a superficial branch that provides sensation over the medial 1½ digits and hypothenar eminence and a deep motor branch that supplies most of the intrinsic muscles of the hand.
The ulnar nerve is most commonly injured at the elbow ("funny bone") due to trauma or nerve compression, but it can also be injured at the wrist as it runs through Guyon's canal. Nerve damage may cause sensory loss in the ulnar distribution with weakness on wrist flexion/adduction, finger abduction/adduction, and flexion of the fourth/fifth digits. The hypothenar eminence can appear flattened due to denervated muscle atrophy. Weakness of the lumbricals in the fourth/fifth digits may also produce an "ulnar claw" deformity during finger extension.
(Choice A) Carpal tunnel syndrome can result from any condition that reduces the size of the carpal tunnel and compresses the median nerve (eg, pregnancy, hypothyroidism). Patients typically have pain/paresthesias affecting the first 3½ digits. Thenar atrophy with weakness on thumb abduction/opposition may also be seen.
(Choice B) The coracobrachialis muscle lies deep to the biceps brachii and is perforated and innervated by the musculocutaneous nerve. Nerve injury may result in decreased strength on forearm flexion and sensory loss over the lateral forearm.
(Choice C) Subluxation of the radial head can injure the deep branch of the radial nerve during its passage through the supinator canal, leading to weakness during finger and thumb extension ("finger drop").
(Choice E) Fracture of the midshaft of the humerus typically results in radial nerve injury leading to paralysis of the hand and finger extensor muscles ("wrist drop") with sensory loss over the posterior forearm and dorsolateral hand.
(Choice F) Fracture of the surgical neck of the humerus may cause axillary nerve injury leading to paralysis of the deltoid and teres minor muscles with sensory loss over the lateral upper arm.
Dopamine Receptor

Osteoporosis Risks

African american less risk
HUS Pathogenesis
Shiga toxin (verotoxin) enters the circulation from the bowel and induces capillary endothelial damage, resulting in platelet activation with the formation of microthrombi. Platelet consumption causes thrombocytopenia whereas the microthrombi lead to erythrocyte damage (forming schistocytes) and the resultant hemolytic anemia (eg, pallor, weakness, tachycardia). Damage to glomerular endothelial cells also causes acute kidney injury (eg, oliguria/anuria, increased creatinine) in approximately 50% of cases.
PCP Histology


Histopathologic and cytologic findings in Pneumocystis jirovecii pneumonia (PCP) include eosinophilic foamy alveolar material (arrow in exhibit) and cystic and trophic forms that can be stained with Giemsa or silver (producing a cup-in-saucerappearance with these stains). In addition, PCP is more common in patients with advanced HIV than in transplant patients and would be unlikely in this patient on PCP prophylaxis with trimethoprim-sulfamethoxazole.
Cervical Cancer Risks

The strongest risk factor for cervical dysplasia (also known as cervical intraepithelial neoplasia) and carcinoma is infection with human papillomavirus (HPV) type 16 or 18.
Individuals with HIV are unable to mount an immune response against HPV due to immunosuppression from T cell deficiency. HIV coinfection may also enhance expression of HPV viral oncogenes E6 and E7, leading to cervical dysplasia/cancer.
(Choice A) Women who have intercourse before age 18 have twice the risk of cervical cancer compared to women who have initial intercourse after age 21.
(Choice B) Alcohol consumption increases the risk of breast cancer but is not associated with cervical cancer. However, tobacco use is a significant risk factor for cervical cancer.
(Choice C) Age at menarche does not affect cervical cancer risk. However, women with menarche before age 12 are at increased risk for breast and endometrial cancers.
(Choice D) Family history of cervical cancer is not a risk factor for cervical dysplasia/cancer. There is no genetic component to cervical dysplasia/cancer as the majority of cervical dysplasias and cancers are caused by HPV, and HPV is a predominantly sexually transmitted infection.
(Choice F) Parity does not affect cervical cancer risk. Anovulatory cycles in nulliparous women increase the risk of endometrial cancer.
Testes Lymph

In general, the lymph drainage from a particular organ follows the path of the arterial supply to that site. During fetal development, the testes originate within the retroperitoneum and establish their arterial supply from the abdominal aorta. The testes subsequently descend through the inguinal canals into the scrotum, taking with them their arterial, venous, and lymphatic supplies. Thus, lymph from the testes drains through lymph channels directly back to the para-aortic (retroperitoneal) lymph nodes.
(Choice A) The superficial inguinal lymph nodes are located on the anterior thigh inferior to the inguinal ligament. These nodes drain nearly all cutaneous structures inferior to the umbilicus, including the external genitalia and the anus up to the pectinate line.
(Choice B) The deep inguinal nodes reside under the fascia lata on the medial side of the femoral vein. They receive afferents from the superficial inguinal nodes and deep lymphatic trunks along the femoral vessels. The lymphatics from the glans penis and clitoris also drain directly to these nodes.
(Choice C) The external iliac nodes drain the superficial and deep inguinal nodes and the deep lymphatics of the abdominal wall below the umbilicus.
(Choice D) The common iliac nodes are located alongside the common iliac artery and drain the internal and external iliac nodes.
(Choice E) The inferior mesenteric nodes drain the structures supplied with arterial blood by branches of the inferior mesenteric artery (eg, the left colic, sigmoid, and superior rectal arteries). Thus, these nodes drain the descending and sigmoid colon as well as the upper part of the rectum. Their efferents drain to pre-aortic nodes.
Klinefelter Hormones

This patient's clinical findings are highly suggestive of Klinefelter syndrome, the most common cause of male hypogonadism. In Klinefelter syndrome, progressive destruction and hyalinization of the seminiferous tubules cause the testes to be small and firm. Serum inhibin levels are decreased as a result of the Sertoli cell damage; Leydig cells are usually dysfunctional as well, resulting inreduced testosterone levels. The loss of feedback inhibition leads to elevated FSH and LH. Patients can also develop high estrogen levels and gynecomastia due to increased aromatase activity (stimulated by the gonadotropin excess).
Most patients with classic (47,XXY) Klinefelter syndrome have azoospermia and are infertile, but those with mosaic variants may have variable degrees of spermatogenesis.
CF Test

Chronic cough and recurrent sinusitis in a young patient of white ethnicity should raise suspicion for cystic fibrosis (CF). The diagnosis of CF typically is based on elevated sweat chloride concentrations, characteristic clinical findings, and/or a positive family history. Although most patients with CF have an elevated sweat chloride concentration, those with mild mutations of the CF transmembrane conductance regulator (CFTR) gene may have normal sweat testing. In these cases, a useful diagnostic adjunct involves measuring the nasal transepithelial potential difference. To understand how this test works, it is necessary to know the tissue-specific effects of the CFTR mutation.
Respiratory and intestinal epithelia: The CFTR protein is a chloride channel that hydrates mucus by secreting chloride ions into the lumen. The increased mucus chloride concentration in turn decreases sodium and water reabsorption into the cell through the epithelial sodium channel (ENaC). In contrast, impaired CFTR function in patients with CF results in reduced luminal secretion of chloride, causing increased luminal sodium and water absorption and ultimately leading to dehydrated, thickened mucus.
Sweat glands: In sweat ducts, the CFTR channel is reversed compared with respiratory and intestinal glands. CFTR reduces the salt content of sweat by absorbing luminal chloride, which leads to increased sodium absorption from the lumen into the cells via the ENaC. CFTR mutations therefore result in the production of sweat with high chloride and sodium content.
During the nasal transepithelial potential difference test, a saline solution is applied to the nose. Because patients with CF have increased sodium absorption via the ENaC (due to the impaired CFTR protein) in their nasal mucosa, sodium will be absorbed intracellularly, but chloride will be retained in the lumen. The result is a more negative test than normal.
Clavicle

This child has a fractured clavicle. The clavicle is the most commonly fractured bone, and the majority of fractures occur in young children.
The clavicle is the point of origin or insertion for numerous muscles, including:
Deltoid - inferolateral aspect
Pectoralis major - inferomedial aspect
Subclavius - inferolateral aspect
Sternohyoid - inferomedial aspect
Trapezius - superolateral aspect
Sternocleidomastoid - superomedial aspect
The sternocleidomastoid muscle is responsible for the upward traction on the medial fragment of the patient's fractured clavicle. The sternocleidomastoid muscle has 3 points of attachment (described in its name): 2 points of origination, "sterno" (the manubrium of the sternum) and "cleido" (the medial part of the clavicle), and its insertion point, "mastoid" (the mastoid process). After a clavicle fracture, the medial fragment is pulled superiorly and posteriorly by the sternocleidomastoid muscle. Similarly, the weight of the arm and the pectoralis major (Choice A) pull the lateral fragment inferiorly and anteriorly.
The pectoralis minor muscle originates on the third, fourth, and fifth ribs and inserts on the coracoid process of the scapula. It does not affect the clavicle.
(Choice C) Both the major and minor rhomboid muscles originate on the vertebral spines and insert on the medial border of the scapula. They cause retraction of the scapulae and do not affect the clavicle.
(Choice D) The serratus anterior muscle originates laterally on the first through eighth ribs and inserts onto the medial border of the scapula. This muscle is innervated by the long thoracic nerve, injury to which causes winging of the scapula.
(Choice E) The sternoclavicular ligaments attach the clavicle to the manubrium. These ligaments hold the medial side of the medial fragment in place, and the sternocleidomastoid muscle pulls the other side of the fragment superiorly.
(Choice G) The subclavius muscle originates on the first rib and inserts on the inferior lateral aspect of the clavicle. It functions to displace the clavicle inferiorly.
(Choice H) The superior fibers of the trapezius originate from the cervical spinous processes and insert on the lateral third of the clavicle. After a fracture, their traction would pull the lateral fragment superiorly, but the combined traction from arm weight and the pectoralis major muscle overcomes the trapezius, resulting in downward displacement.
Blisters

Bullous pemphigoid (BP) is an autoimmune condition characterized by serous fluid-filled, tense bullae on normal or erythematous skin. The most common sites of involvement include the inner thighs, flexor aspects of the forearms, axillae, groin, and lower abdomen. Elderly individuals are most commonly affected.
BP is caused by antibodies against hemidesmosomes along the basement membrane of the dermal-epidermal junction. These autoantibodies result in a destructive inflammatory cascade that causes the entire epidermis to separate from the dermis, formingsubepidermal, nonacantholytic blisters. Immunofluorescence shows IgG and/or C3 deposits in a linear pattern along the basement membrane.
(Choice B) Acute allergic contact dermatitis is characterized by localized erythema, vesicles, edema, and severe pruritus. Biopsy typically shows spongiosis (abnormal accumulation of edema fluid in the intercellular spaces between keratinocytes) and lymphocytic perivascular infiltrates.
(Choice C) Dermatitis herpetiformis is characterized histologically by microabscesses containing fibrin and neutrophils at the dermal papillae tips. The overlying basal cells become vacuolated, and blisters form at the tips of the involved papillae.

(Choice D) Lichen planus causes pruritic, purple papules and plaques involving the skin and mucous membranes. Microscopic analysis shows a lymphocytic infiltrate at the dermal-epidermal junction with destruction of basal epidermal cells.

(Choice E) Pemphigus is due to autoantibodies directed against desmosomal proteins. Biopsy of an active pemphigus lesion will show intraepithelial cleavage with detached keratinocytes (acantholysis), retained keratinocytes along the basement membrane, and an eosinophilic inflammatory infiltrate.
Seizures
simple partial: one half of body + no loss of consciousness
myoclonic: different parts of body, transient jerking + no loss of consciousness
tonic clonic: diffuse contraction and then jerking, loss of consciousness
complex partial: one half of body, lip smacking, automaticity, loss of consciousness
Osteoporosis

Would Healing
Secreted by several different cell types (eg, fibroblasts, macrophages, neutrophils, synovial cells, some epithelial cells), matrix metalloproteinases (MMPs) primarily function in the degradation of collagen and other proteins in the extracellular matrix. MMP activity is important in wound healing, as it encourages both myofibroblast accumulation at the wound edges and scar tissue remodeling. The amassed myofibroblasts initiate wound contraction during healing by second intention. Contractures may occur when unusually pronounced MMP activity results in excessive wound contraction.
Wound dehiscence is the rupturing of a previously closed wound, and can result from insufficient granulation and scar tissue formation, inadequate wound contraction, or excessive mechanical stress. Such wound rupture most commonly occurs in abdominal wounds that are subject to increased intraabdominal pressure, which is not the case with this patient.
Ulceration of a wound typically results from inadequate vascularization during healing and is not associated with excessive matrix metalloproteinase or myofibroblast activity. Common sites of ulceration include lower extremity wounds in conjunction with atherosclerotic peripheral vascular disease.
Local infection is the most important cause of delayed wound healing. The delay results from persistent tissue injury and inflammation and is not known to be specifically related to excessive matrix metalloproteinase or myofibroblast activity.
Keloids are hypertrophic scars in which excessive collagenous scar tissue deposited by fibroblasts permanently extends beyond the margins of the original wound. Keloids are not known to be specifically related to excessive matrix metalloproteinase or myofibroblast activity.
Papillary Necrosis
Sickle cell disease or trait: Sickled cells cause obstruction of small kidney vessels, predisposing to ischemia.
Analgesic nephropathy: Many nonsteroidal anti-inflammatory drugs inhibit renal blood flow by decreasing prostaglandin synthesis and vasoconstricting the afferent arterioles. Certain analgesics can cause ischemia in patients predisposed to renal hypoperfusion.
Diabetes mellitus: Diabetic metabolic abnormalities (eg, nonenzymatic glycosylation) cause changes in vascular walls, leading to renal vasculopathy and subsequent hypoperfusion.
Pyelonephritis and urinary tract obstruction: The edematous interstitium of the pyelonephritic kidney compresses the medullary vasculature, leading to ischemia. In this patient, acute pyelonephritis is unlikely in the absence of fever or costovertebral angle tenderness
Gray-white or yellow necrosis of the distal two-thirds of the renal pyramids is seen macroscopically and corresponds microscopically to coagulation necrosis with preserved tubule outlines; cortical surface scars can develop subsequently as inflammatory foci are replaced by fibrous depressions. Symptoms are due to sloughed papillae (sometimes visible in urine as tissue flecks) and include dark or bloody urine and colicky flank pain (due to ureteral obstruction).
Lead Nephropathy
symptoms
like fanconi
Lumbar

Angular Gyrus

This patient's presentation is consistent with an acute ischemic stroke affecting the angular gyrus of the dominant parietal lobe, a brain region supplied by the middle cerebral artery. The angular gyrus is part of the parietal association cortex, an area that integrates multisensory (eg, visual, tactile, verbal) information to comprehend events and solve problems. Specifically, it is important for semantic processing, word reading and comprehension, and number processing. Damage to this area classically results in Gerstmann syndrome, a neurologic disorder characterized by a constellation of the following signs:
Agraphia (inability to write)
Acalculia (inability to carry out mathematical calculations)
Finger agnosia (inability to identify individual fingers on the hand)
Left-right disorientation
Although Gerstmann syndrome may occur as an isolated syndrome, lesions to the angular gyrus may also be associated with alexia (inability to read) and aphasia (impaired speech).
Hyperlipidemias

NOD2
The pathogenesis of inflammatory bowel disease (eg, Crohn disease, ulcerative colitis) likely involves an abnormal immune response to intestinal microorganisms in genetically predisposed individuals. Numerous genes (including those in the HLA family) have been implicated in this disorder, but mutations in the *NOD2* gene have shown a particularly strong association with Crohn disease.
NOD2 is expressed in epithelial cells and macrophages and helps regulate innate immunity. It encodes an intracellular microbial receptor that recognizes bacterial lipopolysaccharides and subsequently activates the NF-κB pathway. NF-κB is a proinflammatory transcription factor that increases cytokine production. In Crohn disease, mutations in NOD2 result in decreased activity of NF-κB, which impairs the innate immune response of the intestinal mucosa (eg, antimicrobial peptide synthesis, mucin secretion). The loss of this natural barrier defense allows luminal bacteria to penetrate submucosal tissues, causing an exaggerated response by the adaptive immune system that results in chronic gastrointestinal inflammation.

Cyanide vs CO Poisoning

Cyanide inhibits cellular oxidative phosphorylation by inhibiting Fe3+ in cytochrome c oxidase, lowering peripheral tissue oxygen consumption. Arterial PaO2, SaO2, and CaO2 remain unchanged, but venous oxygen content rises and the arterial-venous oxygen gradient falls. Cyanide may also bind to the ferrous (Fe2+) iron of hemoglobin to form cyanohemoglobin, but only in small amounts that do not appreciably change arterial oxygen content.
Type 2a vs 2b
Type II fibers are specialized for generating rapid forceful pulses of movement. Type IIb fibers derive ATP energy through anaerobic glycogenolysis and subsequent glycolysis. Type IIa ("fast twitch") fibers are intermediate between Type I and Type IIb fibers; they generate ATP via aerobic metabolism.
C. Difficile
The toxins bind specific receptors on intestinal mucosal cells and are internalized, allowing them to exert their effects. Both toxins inactivate Rho-regulatory proteinsinvolved in signal transduction and actin cytoskeletal structure maintenance. As a result, the toxins cause disruption of intercellular tight junctions leading to cell rounding/retraction as well as increased (paracellular) intestinal fluid secretion. Both toxins have inflammatory effects (including neutrophil recruitment) and can induce apoptosis. Although these toxins have overlapping activity, toxin A appears to be more enterotoxic and toxin B more cytotoxic.
Ankylosing symptoms
Ankylosing spondylitis is a chronic inflammatory disorder of the sacroiliac joints and axial skeleton. It is most common in young and middle-aged men and presents with morning stiffness and low back pain. Ankylosing spondylitis is characterized by destruction of articular cartilage with resulting stiffness and fusion of axial joints. The sacroiliac joints are often tender to palpation, and the spine may have decreased range of motion. Symptoms improves with position, compared to prostate cancer. X-ray of the sacroiliac joints may reveal erosions, sclerosis, narrowing, and ultimately fusion of the joint spaces. Spine x-rays reveal sclerosis, ligamentous calcification, and vertebral fusion ("bamboo spine").
Beta Thalassemia
Normal adult hemoglobin (hemoglobin A) contains 2 alpha chains and 2 beta chains (α2β2) in combination with heme. Beta-thalassemia affects beta-chain production and can be caused by a variety of DNA mutations affecting the transcription, processing, and translation of beta-globin mRNA. Most commonly, these mutations cause aberrant precursor mRNA splicing or premature chain termination during mRNA translation. In some cases, point mutations prevent RNA polymerase from binding to the promoter region. The resulting beta-globin deficiency occurs in the setting of normal heme and alpha-chain synthesis, leading to increased formation of hemoglobin A2 and (in some patients) hemoglobin F (α2γ2).
Decreased beta-chain synthesis in beta-thalassemia results in the formation of insoluble alpha-chain tetramers that precipitate within red blood cells. This can affect the membrane cytoskeleton and reduce membrane stability.
Midgut Malrotation
Incomplete counterclockwise rotation (eg, 180 degrees) will result in midgut malrotation. The cecum will rest in the right upper quadrant instead of the right lower quadrant (RLQ). Additionally, Ladd's (fibrous) bands connect the retroperitoneum in the RLQ to the right colon/cecum by passing over the second part of the duodenum, causing intestinal obstruction in the process. Obstruction manifests as bilious emesis during the first days of life. In addition, because the mesenteric base is abnormally narrowed, the mesentery is vulnerable to twisting around the superior mesenteric artery. The twisting, referred to as midgut volvulus, compromises intestinal perfusion and may lead to life-threatening bowel necrosis.

Toxins

This patient’s constellation of symptoms (ie, paresthesias, weakness, dizziness, nausea) and history of fish consumption are strongly suggestive of food poisoning by pufferfish, a Japanese delicacy. Pufferfish can be lethal if not properly prepared. It is necessary to remove the organs containing high quantities of tetrodotoxin, a toxin produced by microorganisms associated with the fish.
Tetrodotoxin binds to voltage-gated sodium channels in nerve and cardiac tissue, preventing sodium influx and depolarization. Symptoms of tetrodotoxin poisoning occur quickly after ingestion and include dizziness, weakness, loss of reflexes, paresthesias of the face and extremities, nausea, vomiting, and diarrhea. Higher exposures can cause severe hypotension and general paralysis; death can occur from respiratory failure and hypotension. Treatment includes supportive care and intestinal decontamination with gut lavage and charcoal.
Picks Disease
Frontotemporal dementia (Pick's disease) is characterized by degeneration of the frontal lobes that eventually progresses to include the temporal lobes. Characteristic symptoms include early personality and behavioral changes (eg, disinhibition, apathy, social inappropriateness, compulsive behaviors) and altered speech patterns (eg, paucity of speech, repeated phrases). Neurocognitive deficits occur later in the course of the illness. When evaluating a patient with dementia, frontotemporal dementia should be differentiated from the more common Alzheimer disease, which presents initially with impairment involving recent memory.
Maternal Diabetes

add CV symptoms
Alcohol Hepatitis
Hepatic steatosis is a nonspecific condition characterized by triglyceride accumulation within the hepatocellular cytoplasm. The pathogenesis of alcohol-induced hepatic steatosis appears related primarily to a decrease in free fatty acid oxidation secondary to excess NADH production by the 2 major alcohol metabolism enzymes, alcohol dehydrogenase and aldehyde dehydrogenase. Contributing pathogenetic factors include impaired lipoprotein assembly and secretion and an increase in peripheral fat catabolism. As seen in the image, fatty tissue that is routinely fixed will microscopically demonstrate cytoplasmic vacuoles as the lipid is dissolved during histologic processing. In frozen sections, lipids can be demonstrated by staining with oil red O or Sudan black.
(Choice A) Alcohol-induced hepatic steatosis is associated with increased (not decreased) triglyceride synthesis.
(Choice C) Increased peripheral fat (not phospholipid) catabolism is associated with alcohol-induced hepatic steatosis.
(Choice D) Impaired (not enhanced) lipoprotein assembly is associated with alcohol-induced hepatic steatosis.
(Choice E) The alteration of the hepatic NAD/NADH ratio in alcoholics induces fatty liver through inhibition of gluconeogenesis and fatty acid oxidation.
(Choice F) Increased glucose uptake into cells occurs when high insulin levels are circulating; this condition is not associated with hepatic steatosis.
Bias

Misclassification bias occurs when either the exposure or the outcome is not identified correctly. Random (or nondifferential) misclassification affects all groups to the same extent. For example, if a pediatric size sphygmomanometer cuff is used on all participants (treatment and control groups) as part of a study in adult patients, the blood pressure readings will be incorrect (due to the incorrect cuff size). However, the resulting misclassification will likely affect both groups to the same extent (because the same cuff was used).
Atresia
The more distal the atresia, the more likely it is to present with abdominal distension rather than bilious emesis.
ALS
riluzole
Osgood


Osgood-Schlatter disease (OSD) is an overuse injury of the secondary ossification center (apophysis) of the tibial tubercle. It is a very common cause of knee pain in young adolescent athletes after a recent growth spurt. OSD presents as pain and swelling at the tibial tubercle, the insertion point of the patellar ligament. The patellar ligament connects the tibia to the patella, which in turn is connected to the quadriceps muscles (rectus femoris, vastus intermedius, vastus medialis, vastus lateralis). The quadriceps muscle group is involved in leg extension at the knee. Repetitive quadriceps contraction (eg, jumping) and chronic avulsion cause the proximal patellar tendon to separate from the tibial tubercle. During the healing process, callous formation causes the tubercle to become elevated and prominent.
Sartorius

The sartorius muscle is the longest muscle in the body. It originates from the anterior iliac spine and inserts into the pes anserinus of the anteromedial tibia shaft near the tibial tuberosity. Pes anserinus bursitis commonly occurs in runners and causes anteromedial knee pain.
The tendon of the biceps femoris (part of the hamstrings) inserts at the styloid process of the head of the fibula. The medial condyle of the tibia is the insertion site for the semimembranous muscle, the most medial of the hamstring muscles. The hamstring muscles are involved in knee flexion and hip extension.
Bladder Dysfunction

A 36-year-old woman comes to the office due to frequent urination since an exacerbation of multiple sclerosis 2 months ago. Most of her symptoms, including dizziness, leg weakness, and numbness, have improved with corticosteroid treatment. However, she has continued difficulty holding urine, and on several occasions has passed a small amount of urine while trying to reach the bathroom. She has no urine leakage during coughing or sneezing. The patient has no other medical problems. Her abdomen is soft and nontender. Neurological examination shows hyperreflexia and increased tone in the lower extremities. Her postvoid residual volume is low.
This patient's presentation is consistent with urge incontinence, which is due to detrusor overactivity causing a sudden and/or frequent urge to urinate and empty the bladder. The micturition reflex is an autonomic spinal reflex mediated by both sensory and motor fibers from nerve centers at the S2-S4 levels. Parasympathetic stimulation causes detrusor muscle contraction and internal urethral sphincter relaxation. Sympathetic fibers cause internal sphincter contraction and also help with sensing a full bladder.
Multiple sclerosis (MS) is likely an autoimmune disease that causes varying degrees of demyelination, inflammation, and gliosis in the central nervous system (eg, optic nerves, spinal cord, brainstem, periventricular white matter, and cerebellum). Regions in the pons and cerebral cortex partially inhibit the micturition reflex and also regulate contraction/relaxation of the external urethral sphincter. Spinal cord lesions above the sacral region cause a loss of higher center control of micturition and lead to detrusor hyperreflexia and urge incontinence. Patients typically develop a frequent urge to urinate and pass a small amount of urine. As the disease progresses, the bladder can become atonic and dilated leading to overflow incontinence.
Detrusor muscle weakness:
Overflow incontinence can be due to impaired detrusor contractility or bladder outlet obstruction (eg, tumor obstructing urethra). Patients usually develop involuntary and continuous urinary leakage when the bladder is full and often have incomplete emptying. Post-void residual urine volume is usually high.
Urethral sphincter dysfunction. Pelvic floor laxity
Stress incontinence occurs in patients with sphincter dysfunction or weakness when intraabdominal pressure exceeds the urethral sphincter pressure (eg, sneezing, coughing), causing involuntary urine leakage. This patient's absence of urinary leakage with coughing or sneezing makes this less likely.
HBV Cancer
Although the pathogenesis of HBV-induced hepatocellular carcinoma is still unclear, the integration of viral DNA into the cellular genome of the host is considered a trigger of neoplastic changes. The viral protein HBx activates the synthesis of insulin-like growth factor II and receptors for insulin-like growth factor I, thereby stimulating cell proliferation. Another effect of HBV gene products is suppression of the p53 tumor suppressor / cell cycle regulatory gene in host cells. It is also believed that chronic inflammation and regeneration induced by HBV infection facilitates accumulation of mutations in hepatocytes leading to carcinogenesis. All these events result from integration of the viral genome into host cells.
Hydronephrosis and FF
Bladder neck obstruction causes an increase in Bowman's space hydrostatic pressure thereby decreasing GFR. This too will have no effect on the RPF, but will cause a decreased FF due to the decreased GFR. Contrast this to efferent vasoconstrict that decreases RPF.
Anemia and nails
Iron deficiency anemia may result in physical examination findings that include pallor and koilonychia (spoon-shaped nails), but usually not clubbing.
Clubbing
Clubbing can be primary (idiopathic) or secondary to the following chronic conditions:
Lung diseases: Lung cancer (especially large-cell carcinoma), tuberculosis, cystic fibrosis, bronchiectasis, pulmonary hypertension, empyema, and many other chronic lung diseases associated with hypoxia
Heart diseases: Cyanotic congenital heart diseases 5 Ts, especially tetralogy of Fallot) and bacterial endocarditis
Other: Inflammatory bowel diseases (Crohn's disease, ulcerative colitis), hyperthyroidism, and malabsorption
BRAF

The main environmental risk factor for cutaneous melanoma is increased exposure to ultraviolet radiation (eg, solar or tanning bed sources), which can cause malignant transformation of melanocytes. The risk of melanoma is also increased by mutations in specific genetic factors, most commonly tumor suppressor genes and various oncogenes. BRAF is a protein kinase involved in activating thesignaling pathways of melanocyte proliferation. BRAF mutation V600E (valine → glutamic acid), seen in 40%-60% of patients with melanoma, leads to greatly increased activation of the signaling pathways for melanocyte growth, survival, and metastasis.
Vemurafenib, a potent inhibitor of mutated BRAF, has significant anti-tumor effects with improved survival and long-term outcomes in advanced stage V600E-positive melanoma patients. The presence of this BRAF mutation in this patient's tissue sample most likely indicates a diagnosis of metastatic melanoma.

Medial Circumflex Artery
femoral head primary blood supply

Anaplastic
Anaplastic tumors typically demonstrate the following features:
Significant variation in the shape and size of cells (cellular pleomorphism) and nuclei (nuclear pleomorphism)
Disproportionately large nuclei (high nucleus-to-cytoplasm ratio) that are often deep-staining (hyperchromatic) with abundant, coarsely-clumped chromatin and large nucleoli (example)
Numerous, often abnormal, mitotic figures
Giant, multinucleated tumor cells(Choice A)
Acamprosate
Acamprosate, another abstinence-promoting drug, modulates glutamate neurotransmission at the N-methyl-D-aspartate receptor and is recommended once abstinence has been achieved.
COX

Cyclooxygenase (COX; prostaglandin synthase) initiates the synthesis of prostanoids (eg, prostaglandins, thromboxane) from arachidonic acid]. COX exists in 2 primary forms:
COX 1, which plays a physiologic role in a number of normally functioning tissues (eg, platelets, gastrointestinal tract)
COX 2, which is preferentially expressed at sites of inflammation.
Fanconi
Fanconi anemia is caused by hypersensitivity of DNA to cross-linking agents.
Bloom syndrome is characterized by generalized chromosomal instability. Increased susceptibility to neoplasms is present.
Mullerian Aplasia
This patient is most likely a 46,XX female with Müllerian aplasia, also known as vaginal agenesis or Mayer-Rokitansky-Küster-Hauser (MRKH) syndrome. Aplasia is defined as defective development or congenital absence of an organ or tissue, and patients with MRKH have variable uterine development and no upper vagina (eg, short vagina). As the uterus is hypoplastic or absent, the patient cannot menstruate (eg, primary amenorrhea). Patients with MRKH have normal ovaries, which secrete estrogen normally and enable regular development of secondary sexual characteristics (eg, breast, pubic hair).
Bypass

The normal small intestine is colonized with facultative anaerobes, lactobacilli, enterococci, and gram-positive aerobes. Enteric bacteria can produce vitamins (eg, vitamin K, folate), inhibit proliferation of surrounding pathogenic bacteria, and digest unabsorbed dietary sugars and convert them to fatty acids.
A Roux-en-Y gastric bypass surgery typically creates a small gastric pouch, which is removed from the remainder of the stomach and attached to the jejunum via a gastrojejunal anastomosis. The larger bypassed portion of the stomach and duodenum are reattached to the jejunum distally. This results in a closed-ended gastroduodenal limb, in which bacteria can proliferate and ferment any food that may be diverted into this segment. Small intestinal bacterial overgrowth (SIBO) is characterized by overproduction of vitamin K and folate, associated with nausea, bloating, abdominal discomfort, and malabsorption.
Myxomatous
A research center studying cardiovascular pathology is conducting animal trials in which experimental rabbits are fed sweet peas containing substances that alter connective tissue synthesis and modification. The animals are monitored for several weeks prior to euthanasia. At autopsy, myxomatous degeneration with pooling of proteoglycans in the media layer is observed in the arteries of these animals. These findings are associated with the pathogenesis of which of the following conditions?

Myxomatous changes (pathologic weakening of connective tissue) in the media of large arteries are found in cystic medial degeneration. Medial degeneration is characterized by the fragmentation of elastic tissue ("basket weave" pattern, compared tonormal) and separation of the elastic and fibromuscular components of the tunica media by small, cleft-like spaces that become filled with amorphous extracellular matrix (white arrow).

Marfan syndrome is a frequent cause of cystic medial degeneration in younger patients. It is characterized by an autosomal dominant defect in the extracellular glycoprotein fibrillin-1. Fibrillin-1 is a major component of extracellular matrix microfibrils, which form the scaffolding for elastic fibers. Mutation of the fibrillin-1 gene predisposes to aortic aneurysms and dissections.
β-aminopropionitrile (a chemical found in certain kinds of sweet peas) causes inhibition of lysyl oxidase, an enzyme responsible for cross-linking elastin fibers and collagen fibers. Ingestion of this compound can cause a change in the elasticity of the aorta that mimics the myxomatous degeneration seen in patients with Marfan syndrome.
Atherosclerosis is the formation of intimal atheromas in response to chronic/repetitive endothelial injury. Myxomatous degeneration does not play a significant role in the pathogenesis of atherosclerosis.
Giant cell arteritis (GCA) involves granulomatous inflammation of the media and fragmentation of the internal elastic lamina, perhaps due to autoimmunity to elastin. GCA is not related to myxomatous changes of the arterial wall.
Fanconi Anemia
Fanconi anemia is an autosomal recessive condition caused by mutations in the genes responsible for the repair of interstrand DNA crosslinks. It is the most common inherited cause of aplastic anemia and presents with short stature, absent thumbs, and increased malignancy risk.
Ergotamine
Dihydroergotamine is an ergot alkaloid commonly used to treat acute migraine headache. This drug may induce vasospastic angina as it constricts vascular smooth muscle via stimulation of both alpha-adrenergic (partial agonist) and serotonergic receptors. Other possible triggers include cigarette smoking, cocaine/amphetamines, and triptans.
Supracondylar

Supracondylar humeral fractures are common pediatric elbow fractures that often occur after hyperextension injuries (eg, falling onto an outstretched arm). These fractures carry a significant risk of neurovascular compromise, particularly if the fracture is displaced.
The brachial artery, median nerve, and radial nerve all run anterior to the elbow with the brachial artery and median nerve running together medially and the radial nerve running laterally. Due to this configuration, supracondylar fractures resulting in anterolateral displacement of the proximal fracture fragment typically cause radial nerve injury. This causes wrist drop (due to denervation of hand/finger extensor muscles) and sensory loss over the posterior forearm/dorsolateral hand.
Supracondylar fractures resulting in anteromedial displacement of the proximal fracture fragment typically cause median nerve and brachial artery injury. Patients with proximal median neuropathy can have sensory loss over the first 3 digits and weakness on thumb flexion/opposition, flexion of the second/third digits, and wrist flexion/abduction. Brachial artery injury may result in a pulseless hand due to vascular insufficiency.
The 2 heads of the biceps muscle originate from the scapula and insert on the radius. Biceps tendon injury and rupture typically occur in older individuals following sudden extension of a flexed elbow while contracting the biceps (eg, lifting a heavy object).
The ulnar nerve runs immediately posterior to the medial epicondyle and can be injured with hyperflexion injuries (eg, falling onto a flexed elbow), causing posterior displacement of the proximal humerus or fracture of the medial epicondyle. Proximal ulnar neuropathy often presents with sensory loss over the medial 1½ digits and weakness on flexion of the fourth/fifth digits and wrist.
Opioid Allergy
This patient with acute pruritus following administration of morphine most likely has medication-induced IgE-independent mast cell activation. A number of medications, including opioids, radiocontrast agents, and some antibiotics (eg, vancomycin), can induce mast cell degranulation by activation of protein kinase A and PI3 kinase. This results in release of several mediators, including histamine, bradykinin, heparin, and a number of enzymes and chemotactic factors. Common symptoms include diffuse itching and pain, bronchospasm, and localized swelling (urticaria).
CFR
Case-fatality rate (CFR) is a measure of the severity of a disease or condition. It is defined as the proportion of reported cases of a specific disease or condition (eg, methicillin-resistant S aureus, [MRSA]) that are fatal within the population affected by the disease or condition over a specific time. The CFR can be calculated as the number of fatal cases of disease or condition divided by the total number of people with the disease or condition.
In this scenario, 40 fatal and 70 nonfatal cases of MRSA infection are reported. Therefore, the CFR is:
CFR = 40 / (40 + 70) = 40 / 110
CaSR

Calcium-sensing receptors (CaSR) are transmembrane G-protein-coupled (metabotropic) receptors that help to regulate the secretion of parathyroid hormone (PTH) in response to changes in circulating calcium levels. Binding of calcium to CaSR leads to inhibition of PTH release, whereas low calcium levels lead to increased PTH release.
Last updated
